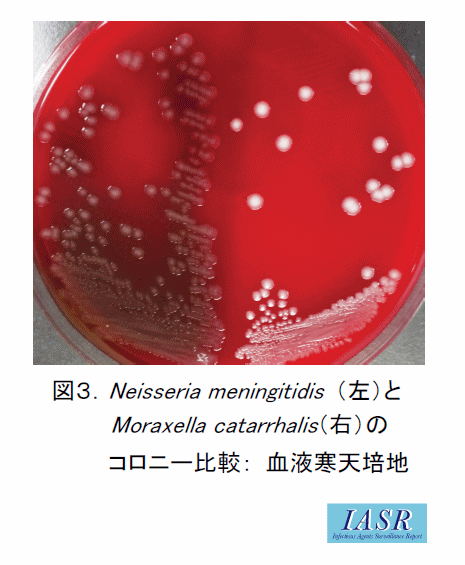
菌種別 <span class=
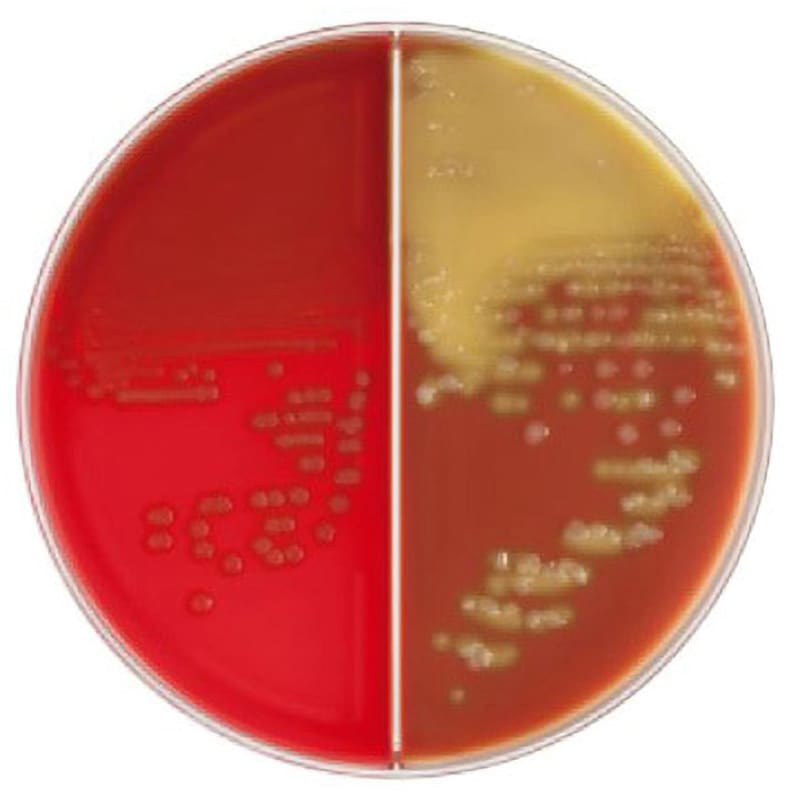
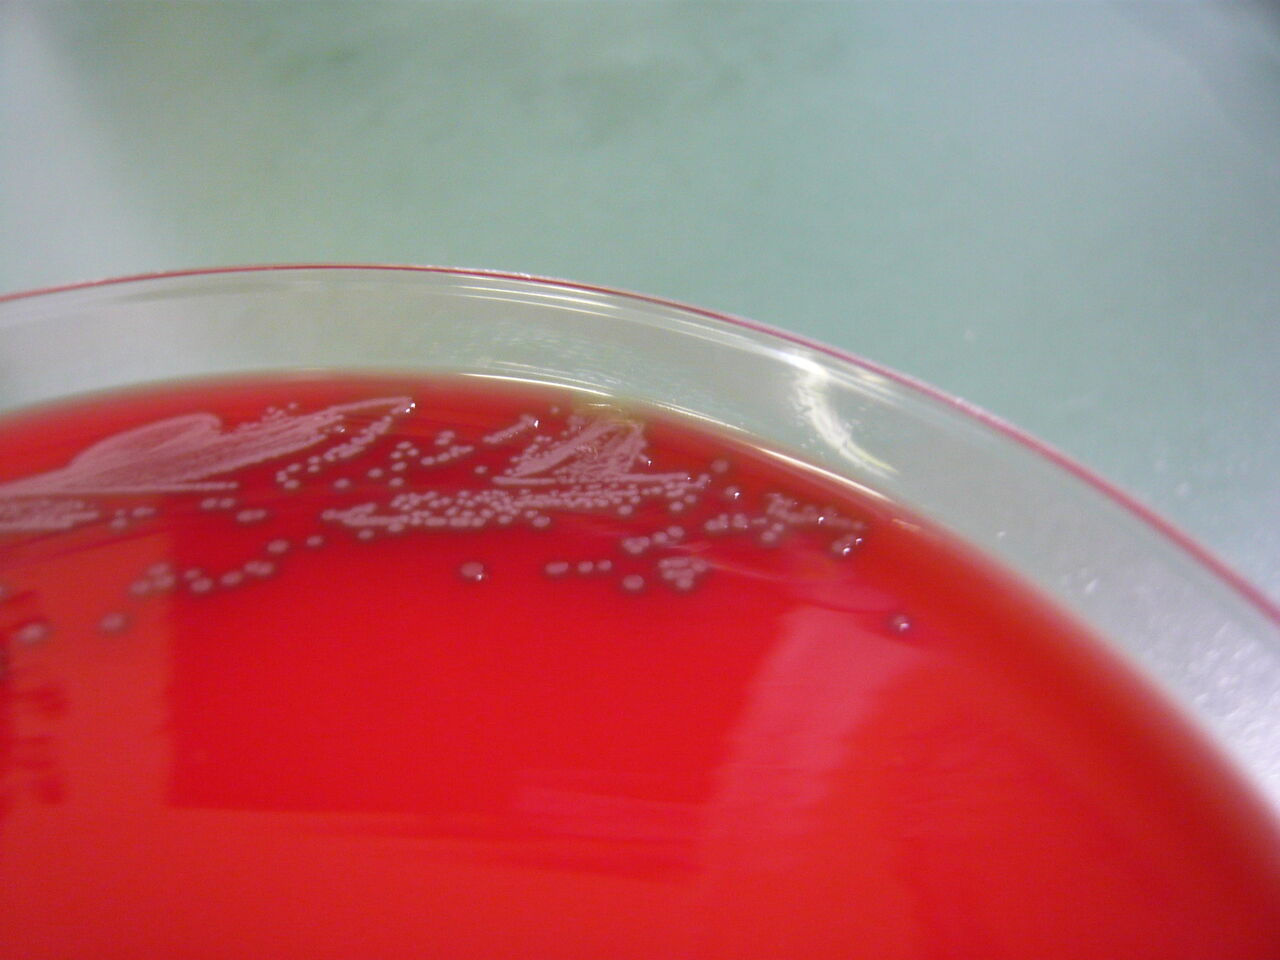
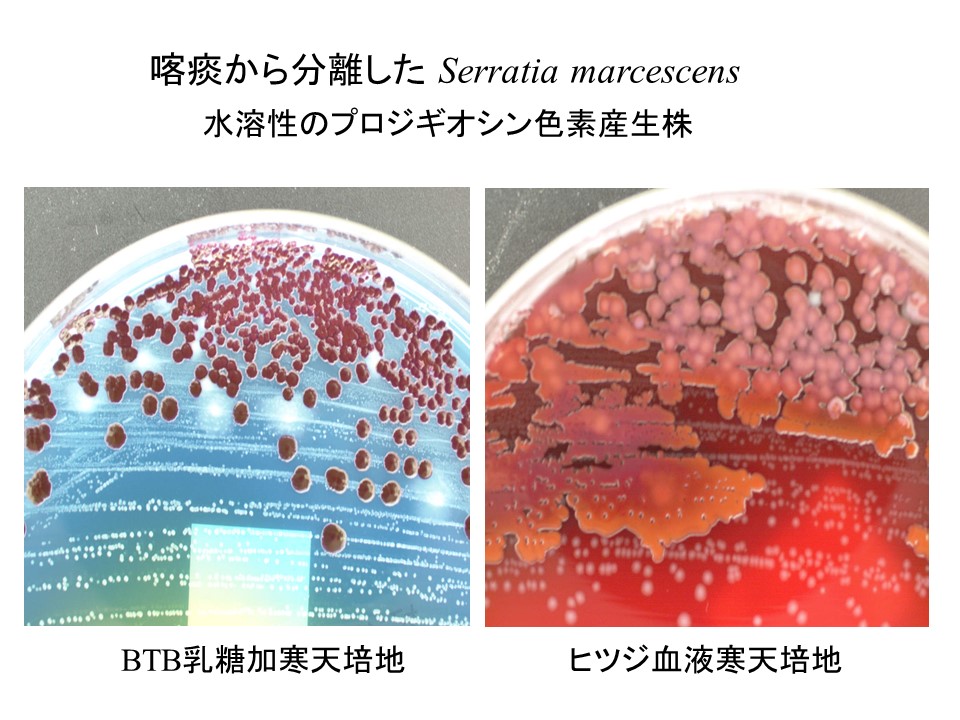
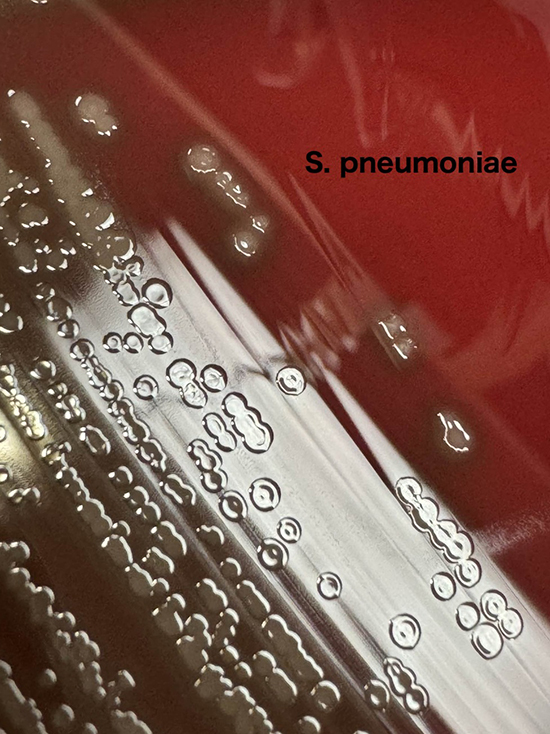
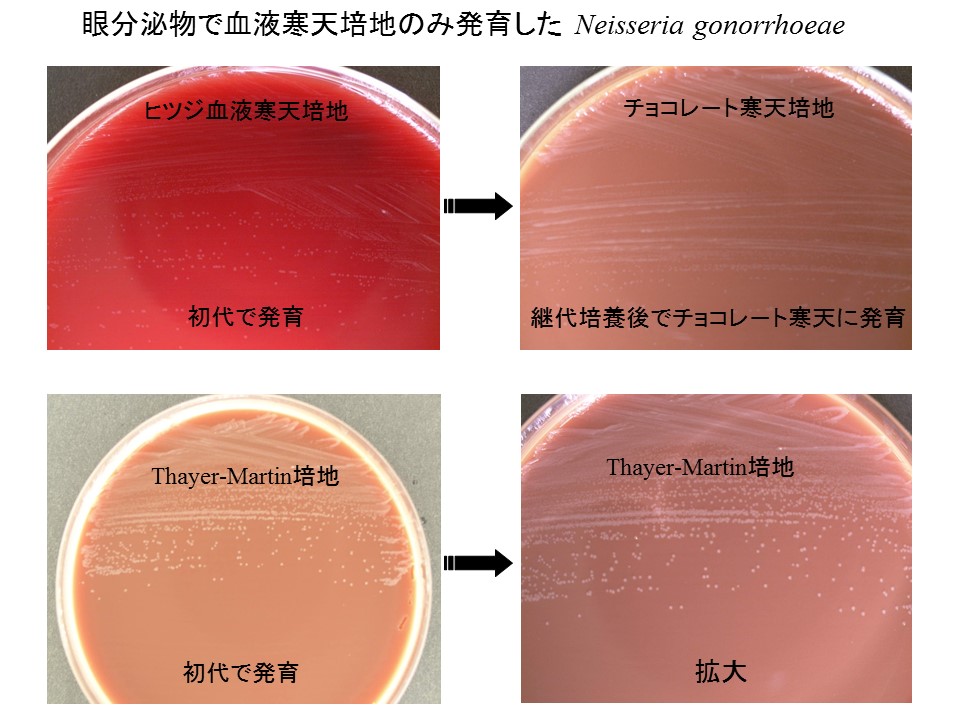
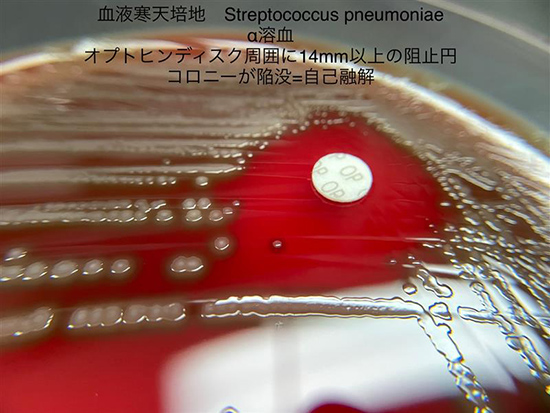
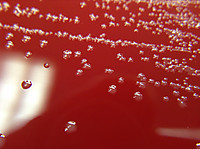
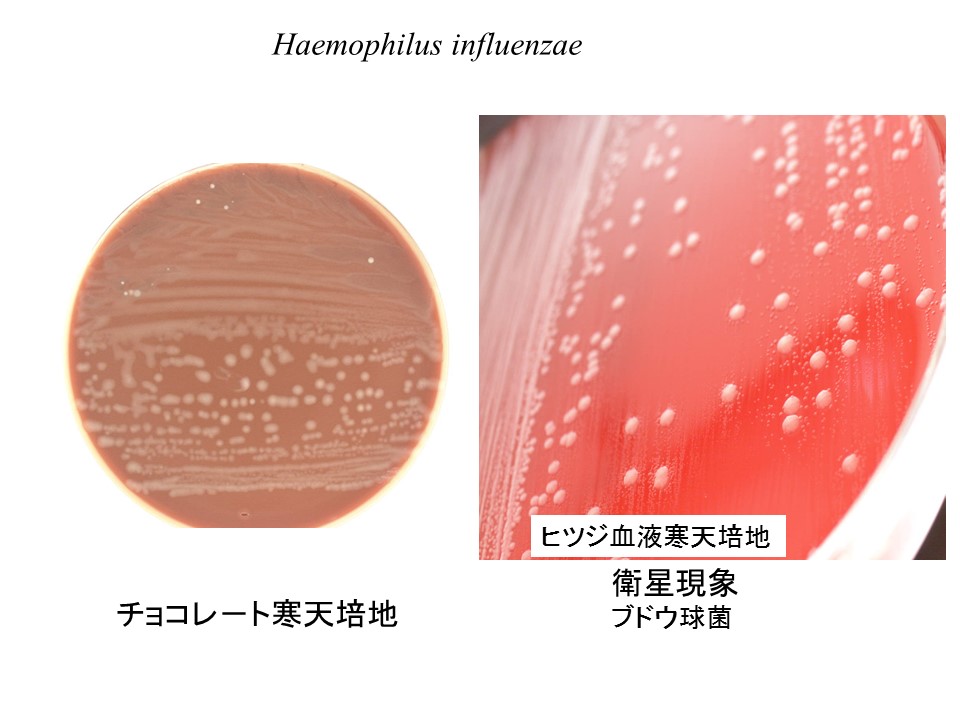
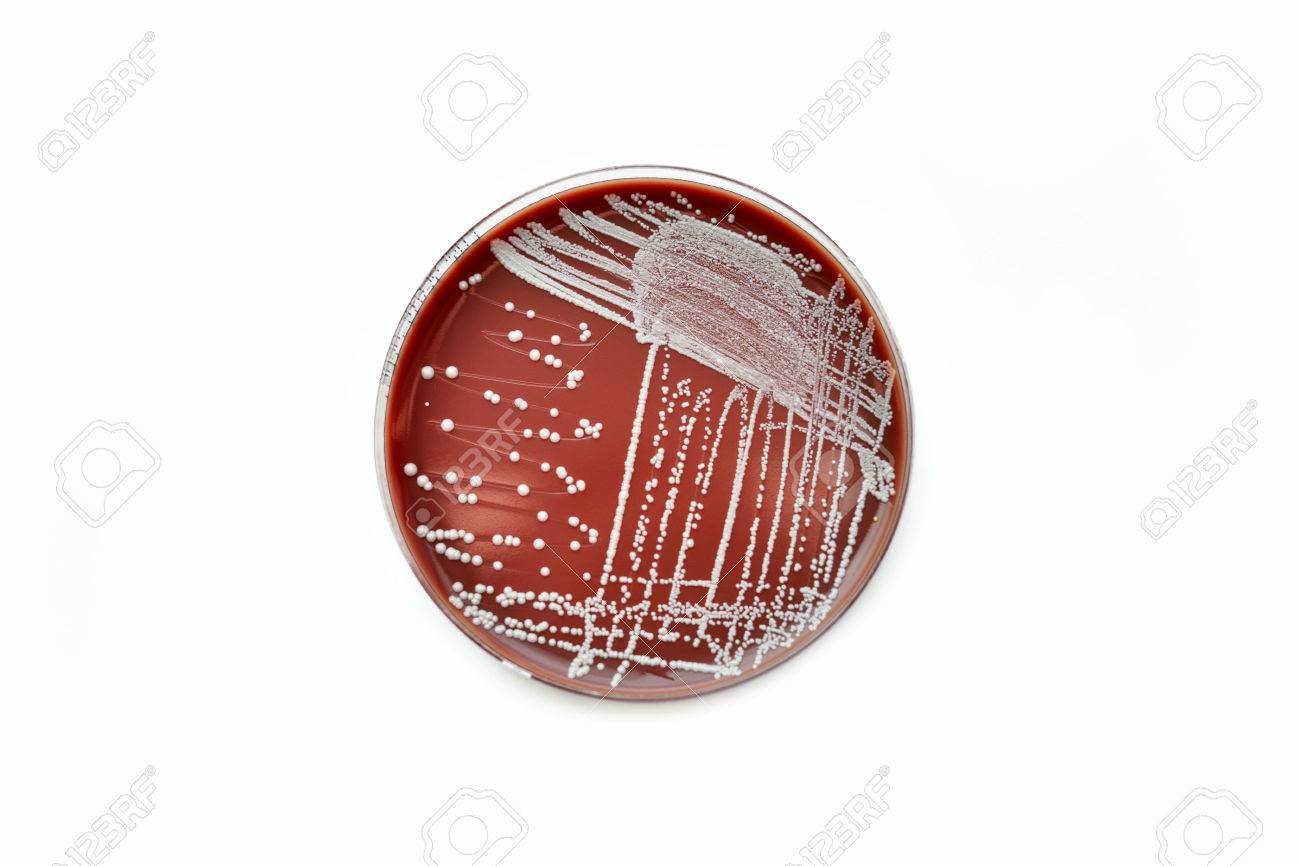
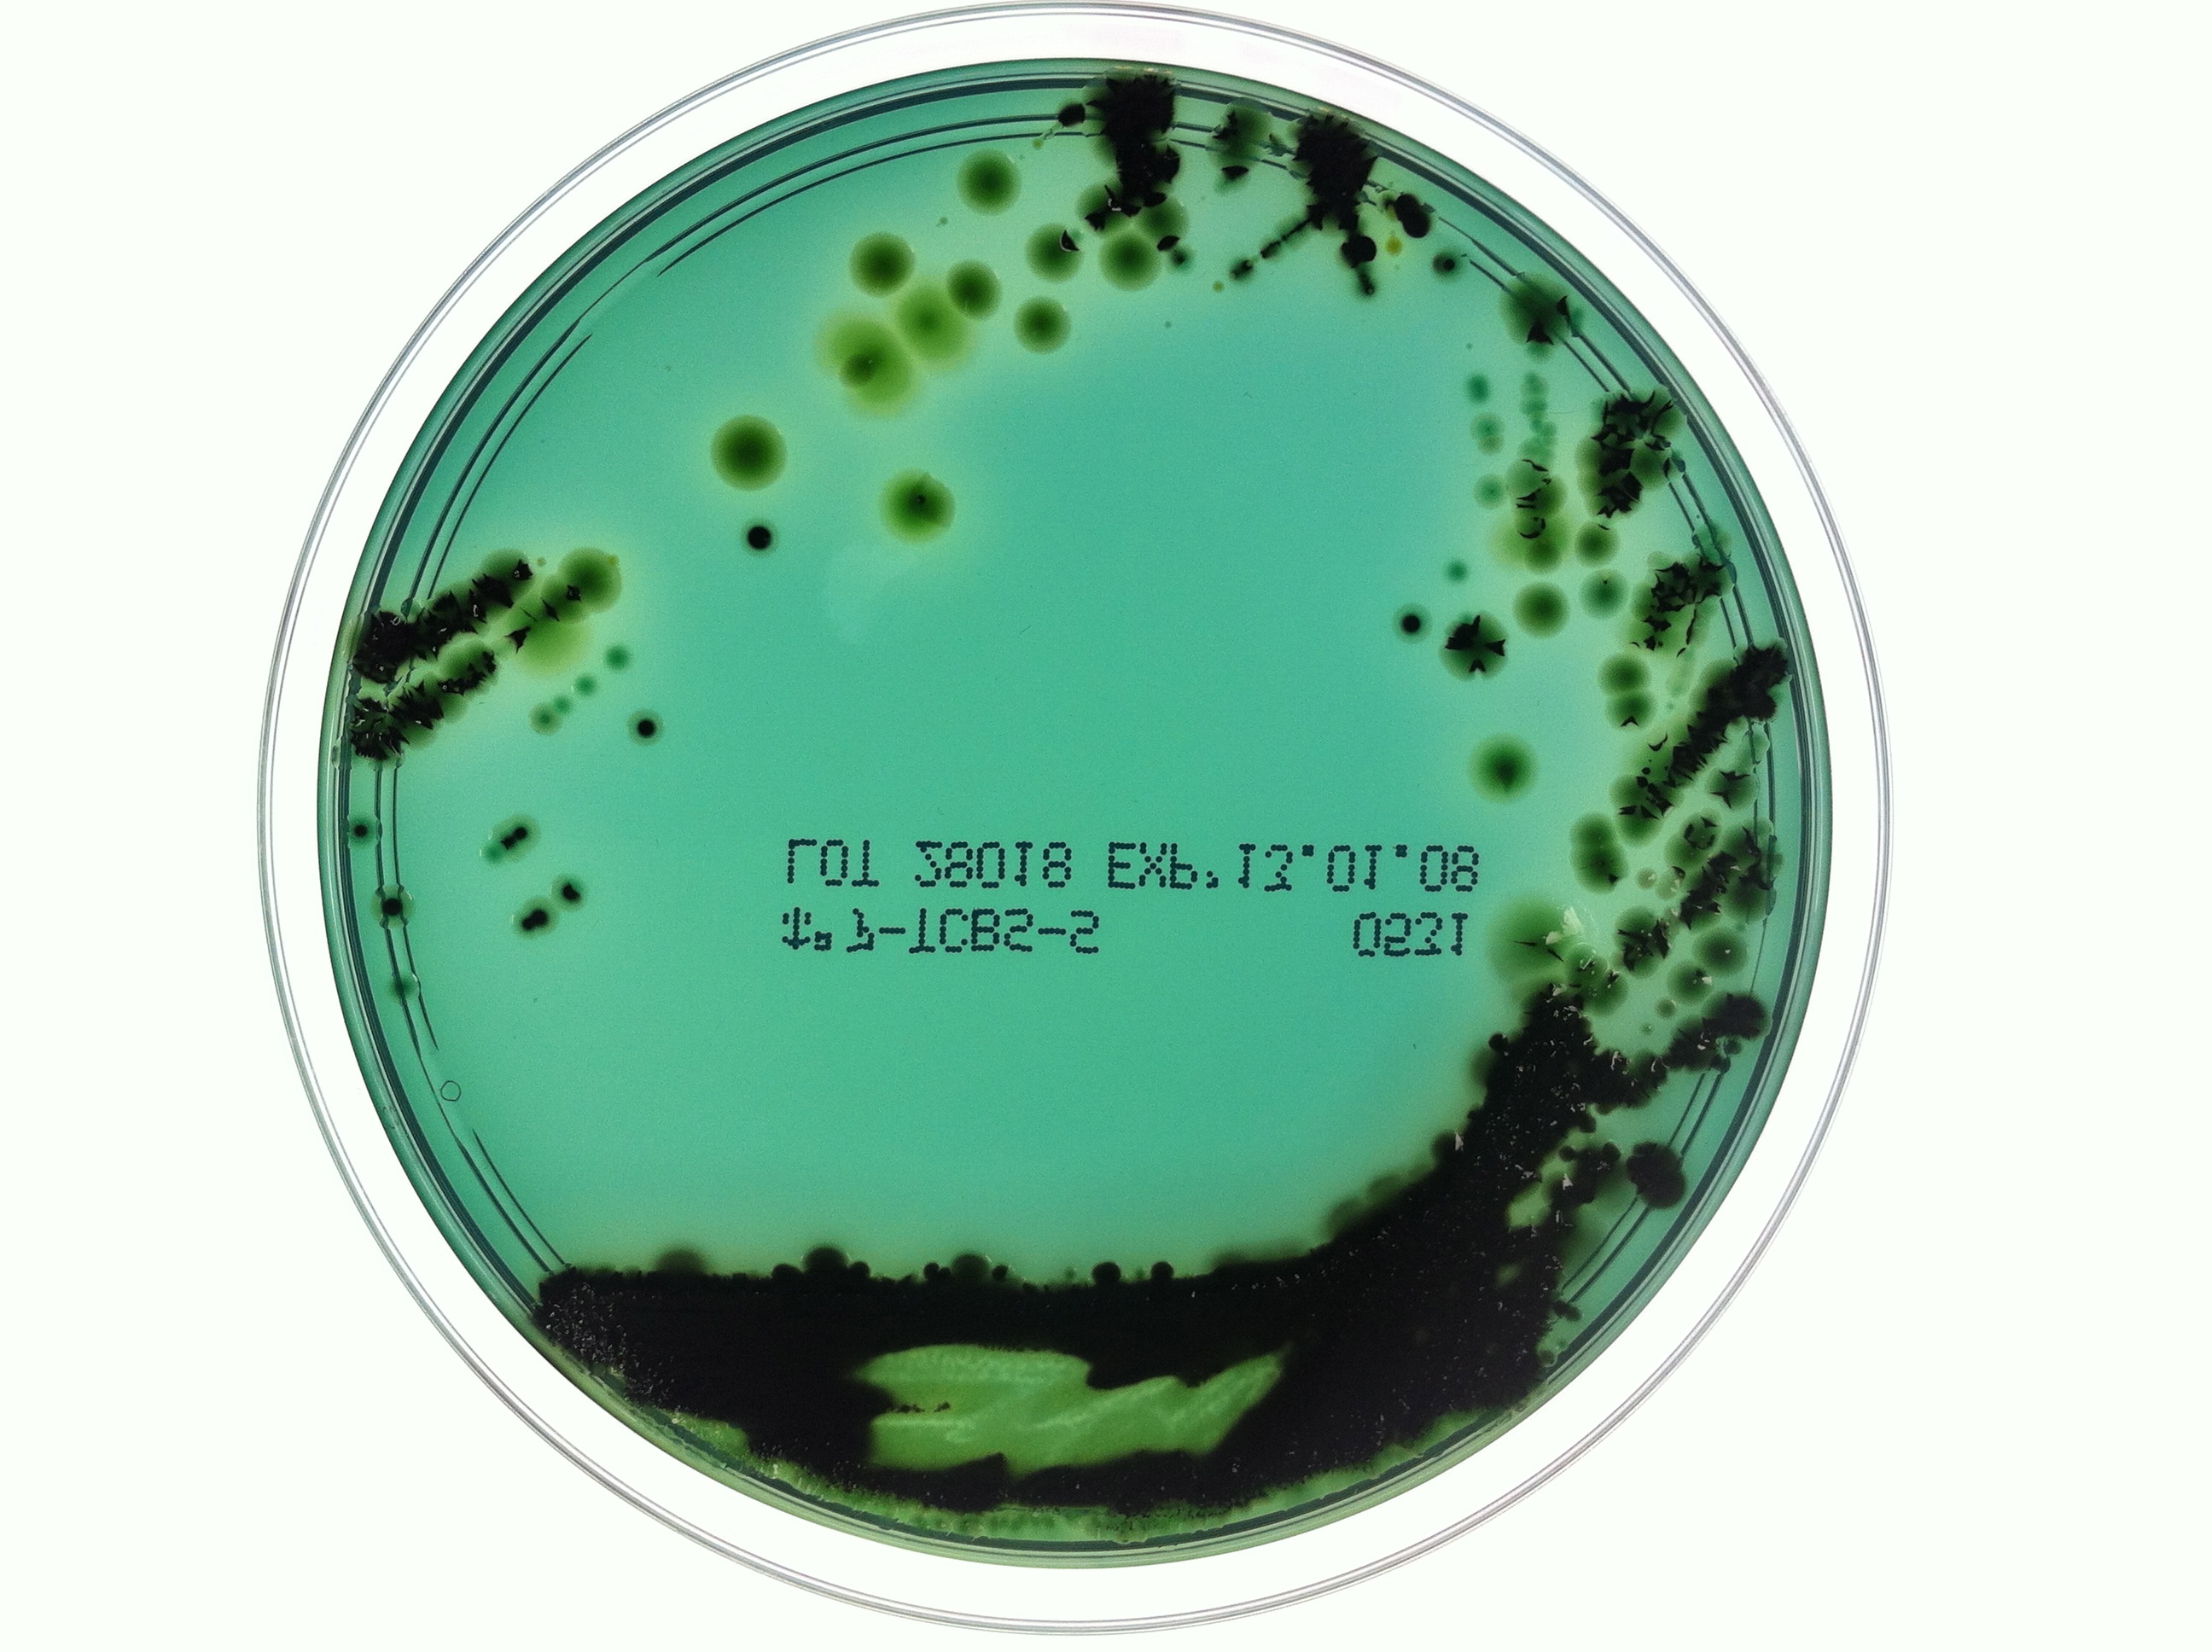
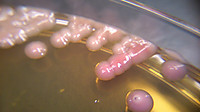
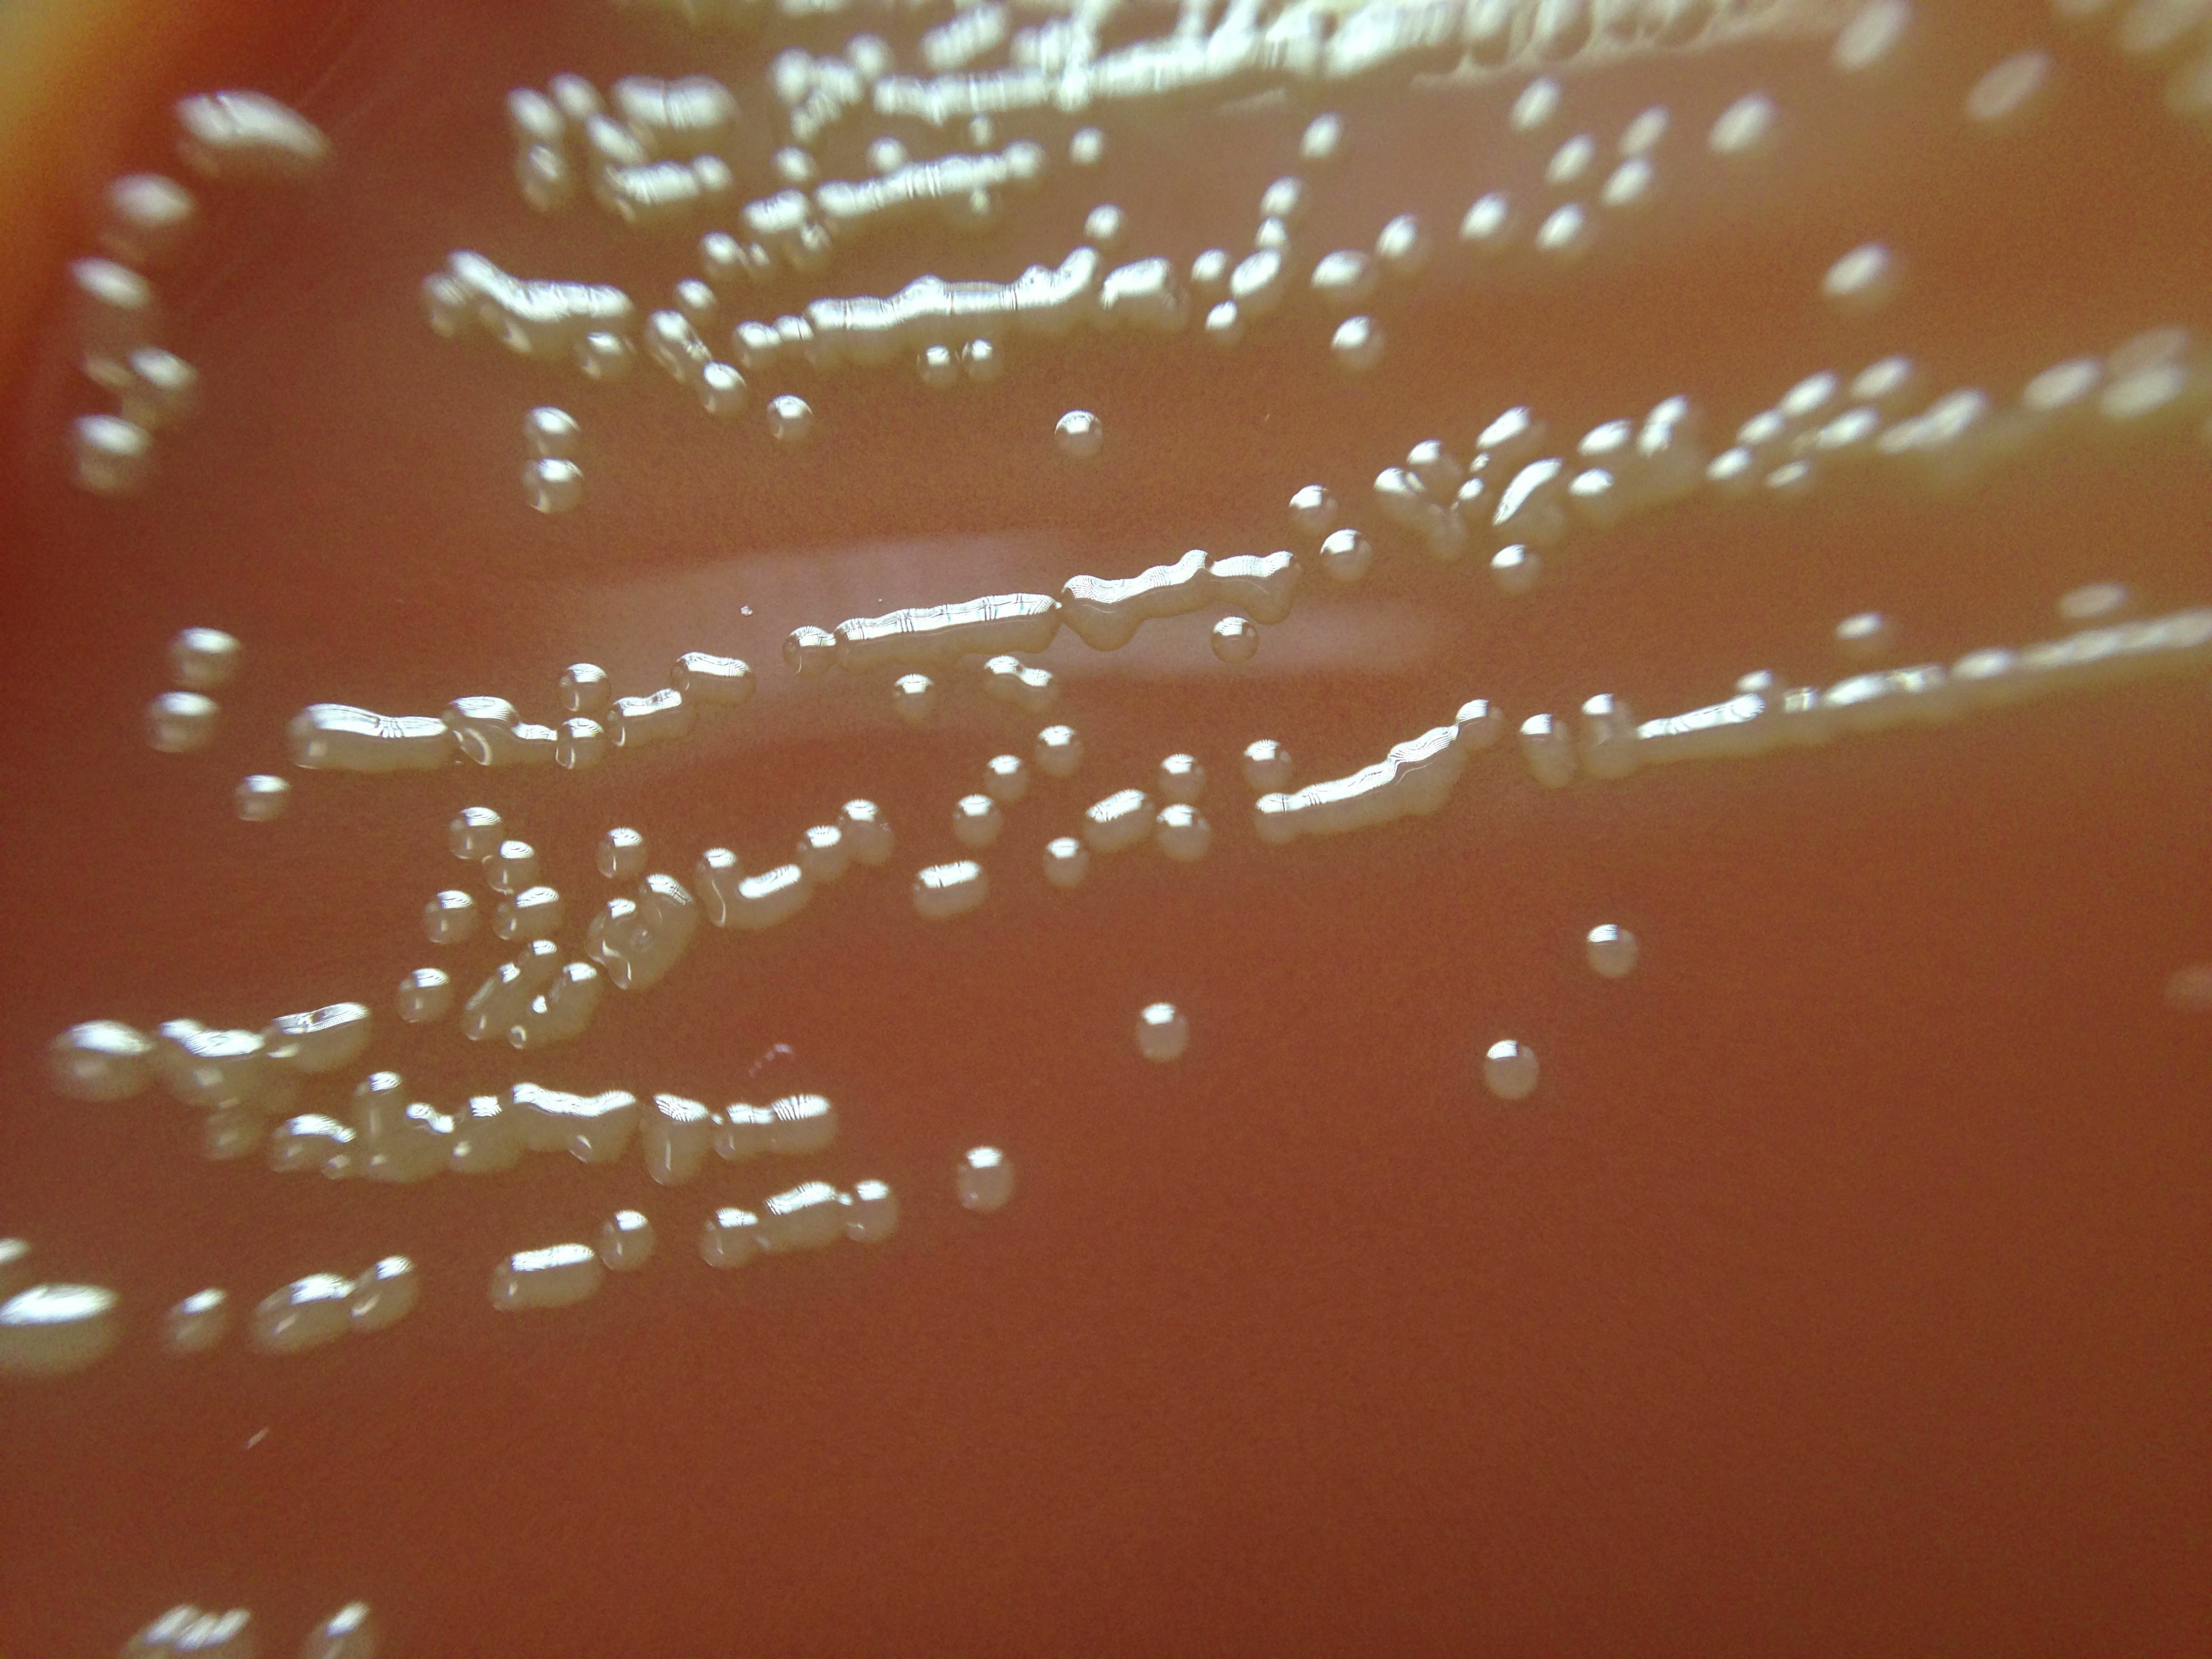
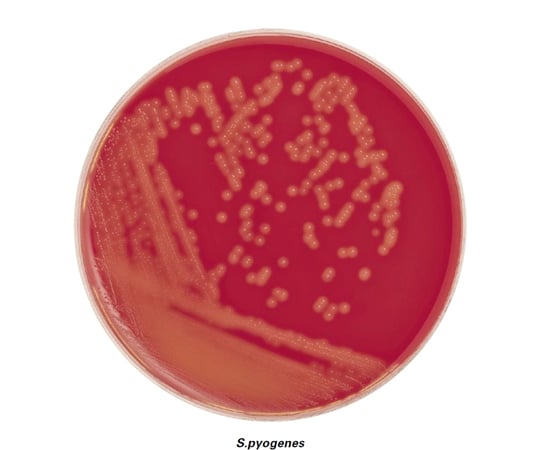
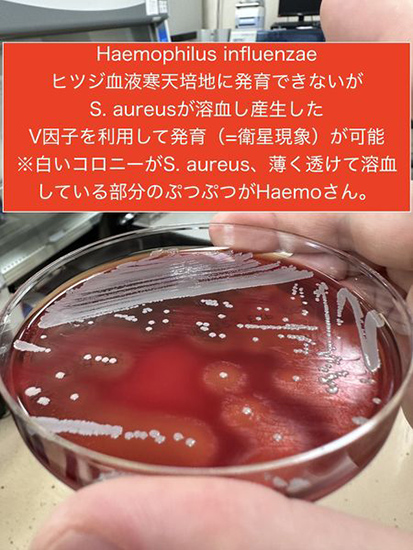
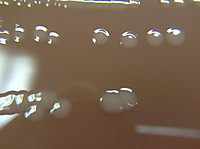
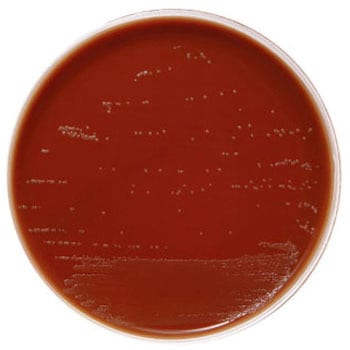
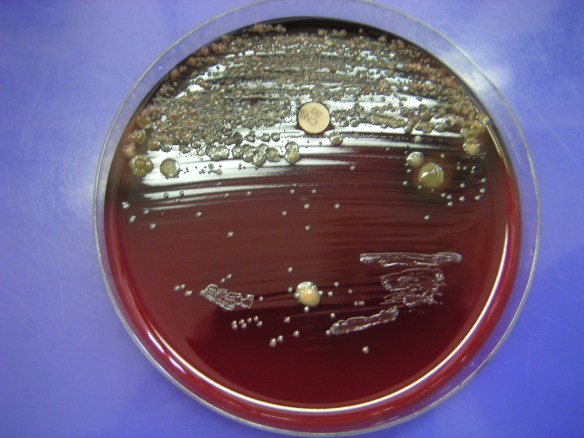
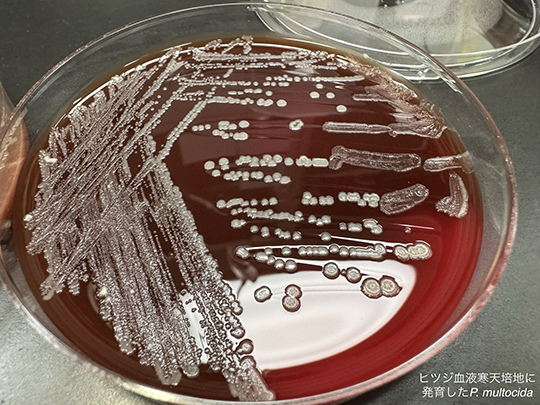

チョコレート寒天培地 血液寒天培地 違い (322 無料画像)
H.influenzae N.gonorrhoeae の発育支持性能アップ H.influenzae ②N.gonorrhoeae③S.pneumoniae ④M.cata。
最近の改良血液寒天培地にみる性能の変化検査と技術 25巻6号医書.jp。

Serratia< span>属_微生物検査検査・診断Matrix" loading="lazy" >
ダウンロード
菌種別 Serratia< span>属_微生物検査検査・診断Matrix。
培地物語 血液寒天培地 前編血液は何でも良いのか?: グラム染色道場。
栄研化学 ポアメディアRチョコレート寒天培地II 10枚入 E-MS50 1パック 10枚65-9539-12 直送品- アスクル。
アキュレート™ 分画 CA羊血液寒天 VCMチョコレートEXⅡ臨床診断薬分野 医療関係者向けサイト島津ダイアグノスティクス株式会社。
microbiology round - 亀田総合病院 感染症内科。
培地物語 血液寒天培地 前編血液は何でも良いのか?: グラム染色道場。
菌種別 Staphylococcus属_微生物検査検査・診断Matrix。
微生物 Photo 問題 設問1 設問2 設問3 1000 養 写真 2-4:BTB 乳糖加寒天培地、35℃、72 時間培養。
一般細菌用 - TSAI15% ヒツジ血液寒天培地 - カタログ番号 251239。
一般細菌用 - TSAI15% ヒツジ血液寒天培地 - カタログ番号 251239。
チョコレート寒天培地とは!?🍫 - YouTube。
一般細菌用 - TSAI15% ヒツジ血液寒天培地 - カタログ番号 251239。
アキュレート™羊血液寒天培地ーN10枚51001。
細菌一般培養検査の基本的な培地は、血液寒天培地、チョコレート寒天培地および BTB乳糖加寒天培地 : 感染症の病理学的考え方。
アキュレート™ 羊血液寒天培地HEM臨床診断薬分野 医療関係者向けサイト島津ダイアグノスティクス株式会社。
BD BBL TM TSAⅡ5%ヒツジ血液寒天培地 チョコレートⅡ寒天培地 冷蔵。
H.influenzae N.gonorrhoeae の発育支持性能アップ H.influenzae ②N.gonorrhoeae③S.pneumoniae ④M.cata。
特別企画 臨床検査技師国試過去問解説シリーズ39 - カーブジェン+。
Amazon栄研化学 ポアメディア R チョコレート寒天培地 10枚入 E-MP31寒天培地産業・研究開発用品 通販。
チョコレート寒天培地の作り方検査と技術 12巻11号医書.jp。
チョコレート寒天培地で細菌のコロニーの写真素材・画像素材 Image 79504544。
亀田総合病院 感染症内科 - 血液寒天培地に発育したS. argenteusFacebook。
日々の検査から No.10じんりんぎ 微生物研究班。
びせいぶつけんさトリビアじんりんぎ 微生物研究班。
培地物語 血液寒天培地 前編血液は何でも良いのか?: グラム染色道場。
Amazon島津ダイアグノスティクス 生培地 アキュレート 羊血液寒天培地 10枚寒天培地産業・研究開発用品 通販。
アキュレート™ 分画 羊血液寒天 チョコレートEXⅡ臨床診断薬分野 医療関係者向けサイト島津ダイアグノスティクス株式会社。
普通寒天培地に発育しない細菌検査と技術 14巻3号医書.jp。
びせいぶつけんさトリビア No.6じんりんぎ 微生物研究班。
チョコレート寒天培地中での抗菌感受性試験微生物学研究室での抗生物質感受性試験チョコレート血液寒天 - カラー画像のストックフォトや画像を多数ご用意 -iStock。

Neisseria< span>属_微生物検査検査・診断Matrix" loading="lazy" >
ダウンロード
菌種別 Neisseria< span>属_微生物検査検査・診断Matrix。
チョコレート寒天培地プレートのナイセリア淋菌細菌のコロニーの写真素材・画像素材 Image 65689373。
microbiology round - 亀田総合病院 感染症内科。
島津ダイアグノスティクス アキュレート TM チョコレート寒天培地―EXII10枚 51053 1個 10枚65-9404-81 直送品-アスクル。
REF43 561 ヘモフィルス チョコレート寒天培地HAEM。
培地物語 血液寒天培地 前編血液は何でも良いのか?: グラム染色道場。
亀田総合病院 感染症内科 - 5%ヒツジ血液寒天培地に発育したAspergillus fumigatusFacebook。
Haemophilus属が血液寒天培地に発育困難である理由臨床検査 39巻12号医書.jp。
BD BBL TM ヒツジ血液寒天培地 T 冷蔵 一般細菌用。
Amazon島津ダイアグノスティクス 生培地 アキュレート チョコレート寒天培地EXⅡ 10枚寒天培地産業・研究開発用品 通販。
BD BBL TM BYチョコレート寒天培地 ベクトン・ディッキンソン通販モノタロウ。
BD BBL TM TSAⅡ5%ヒツジ血液寒天培地 BTB乳糖加寒天培地 冷蔵。
培地物語 血液寒天培地 前編血液は何でも良いのか?: グラム染色道場。
培地物語 血液寒天培地 前編血液は何でも良いのか?: グラム染色道場。
 Serratia< span>属_微生物検査検査・診断Matrix" loading="lazy" >
ダウンロード
Serratia< span>属_微生物検査検査・診断Matrix" loading="lazy" >
ダウンロード Neisseria< span>属_微生物検査検査・診断Matrix" loading="lazy" >
ダウンロード
Neisseria< span>属_微生物検査検査・診断Matrix" loading="lazy" >
ダウンロード